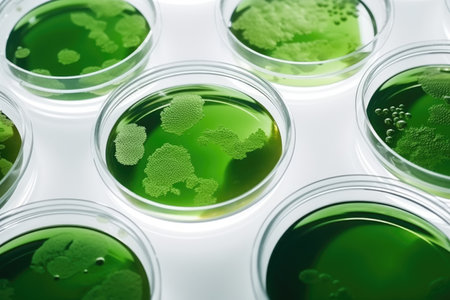

素材 - Algae, microalgae in petri dishes research in laboratories. biotechnology, science. Flat lay, top view. macro. Biofuel research process in laboratory. Generative AI
作品情報
Algae, microalgae in petri dishes research in laboratories. biotechnology, science. Flat lay, top view. macro. Biofuel research process in laboratory. Generative AI
- ID:206324116
- 作品種別:
- 作者名:iloli
キーワード
- alga
- algae
- alternative
- background
- biodiesel
- biofuel
- biology
- biotechnology
- bottle
- cell
- color
- control
- culture
- education
- energy
- environment
- equipment
- experiment
- extraction
- fuel
- green
- industrial
- industry
- lab
- laboratory
- life
- light
- marine
- microalgae
- natural
- nutritious
- oil
- photobioreactor
- plant
- plastic
- plate
- process
- production
- research
- sample
- science
- scientific
- small
- study
- sustainable
- system
- technology
- tool
類似作品
Close up of Pet...
Petri dishes fi...
liquid micro al...
Algae, microalg...
Lawn mower, gra...
Laboratory glas...
Closeup Petri D...
a green lefe in...
Genetically mod...
Colony of blue ...
Algae, microalg...
3D rendering of...
Green broccoli ...
Fresh broccoli ...
surface algae p...
Backgrounds of ...
Close up of Asp...
Close-up of gre...
microbial cultu...
lab with unique...
Experimental la...
Vibrio parahaem...
Education of ch...
Petri dishes wi...
Close-up of cul...
microbial cultu...
aerial view of ...
biofuel laborat...
Laboratory Glas...
Close-up of cul...
Laboratory test...
Photobioreactor...
Plants in petri...
Algae, microalg...
Drink and lime ...
The screened Um...
Closeup for pla...
Vibrant green l...
Plate with fres...
epidemic and th...
Serpentine - r...
cropped image o...
Petri dishes wi...
Green smoothie ...
Rows of vibrant...
Perfect green r...
Culture in a pe...
Science, resear...
closeup seaweed...